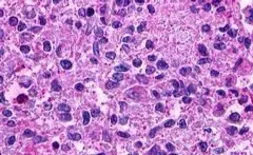
Anti-LGR5 antibody used in IHC (Paraffin sections) (IHC-P). GTX71143

5 Search results for
NP_003658
Product
Images
Description
Applications
Reactivity
Price
-
![Anti-LGR5 antibody [HL4443] used in Western Blot (WB). GTX644008 Anti-LGR5 antibody [HL4443] used in Western Blot (WB). GTX644008](/upload/website/prouct_img/small/GTX644008/GTX644008_45894_20251010_WB_KO_watermark_25102220_112.webp) Description Rabbit MonoclonalApplications WBReactivity Hu
Description Rabbit MonoclonalApplications WBReactivity HuSummary This antibody was raised against human LGR5 Extracellular domain.
$419100μl$16925μl -
$419100μl$16925μl
-
![Anti-LGR5 antibody [GT11312] used in Western Blot (WB). GTX631935 Anti-LGR5 antibody [GT11312] used in Western Blot (WB). GTX631935](/upload/website/prouct_img/small/GTX631935/GTX631935_44706_20220722_WB_B_22080119_774.webp) Description Mouse MonoclonalApplications WBReactivity Hu, Ms
Description Mouse MonoclonalApplications WBReactivity Hu, MsSummary Orthogonal validation was supported by references (PMID:30224759)
$419100μl$16925μl -
$419100μl
-
$41925μg
 Recombinant antibody
Recombinant antibody
 KO/KD
KO/KD
 Orthogonal
Orthogonal
 Overexpression
Overexpression